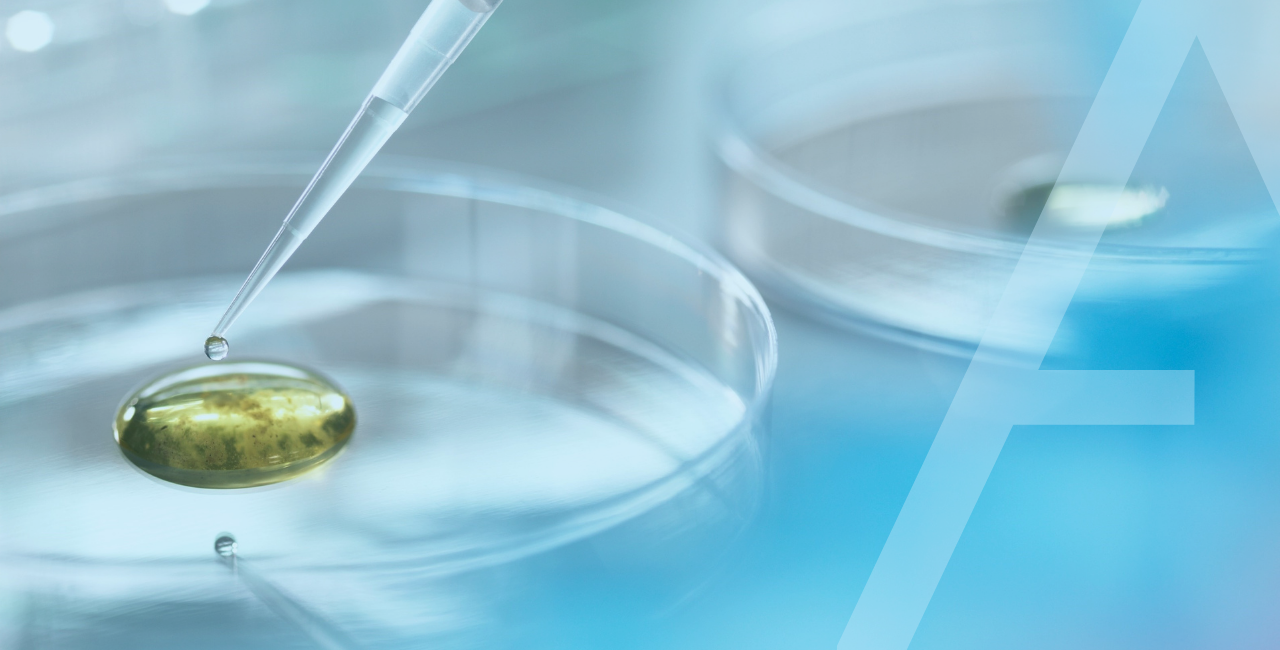

Over the past three years, NBS Scientific USA has experienced significant growth across various market segments. To accommodate this growth, and to further develop existing market segments, they’ve added several new members to their team – specifically in their Sales and Logistics departments.
As their team expanded, NBS Scientific searched for additional office space that would allow for even more growth in the future. For this reason, in March of 2021, they purchased a second suite in the Ashwood Commons Office Park. Their new suite includes 12 offices, two large meeting spaces, a conference room, and a kitchenette. After weeks of preparation, NBS Scientific USA officially “opened” their new office space on August 9th, 2021.